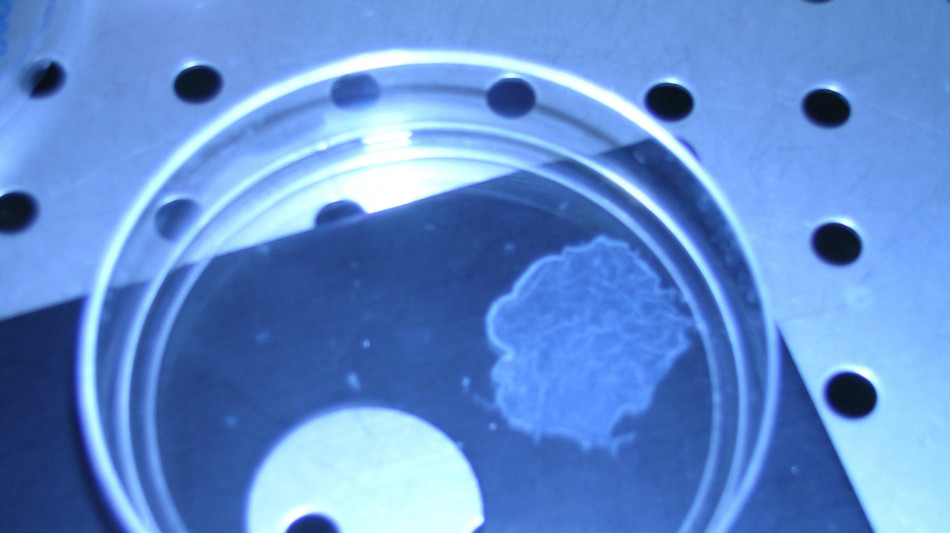
C'è un legame tra rigidità dei tessuti e progressione dei tumori

C'è un legame tra rigidità dei tessuti e progressione dei tumori
I meccanismi molecolari scoperti da uno studio guidato dal Cnr
Le cellule percepiscono gli stimoli meccanici provenienti dall'ambiente circostante e modulano il trasporto e la secrezione di proteine in risposta alla rigidità dei tessuti: la scoperta, che ha importanti implicazioni per il trattamento di fibrosi e tumori, è pubblicata sulla rivista Advanced Science da un team internazionale guidato dal Consiglio nazionale delle ricerche. Ne fanno parte i ricercatori dell'Istituto di nanotecnologia del Cnr di Lecce e dell'Istituto degli endotipi in oncologia, metabolismo e immunologia del Cnr di Napoli, in collaborazione con l'Istituto Telethon di Genetica e Medicina (Tigem), la Fondazione Istituto nazionale di genetica molecolare, l'Università degli Studi di Milano, la Scuola politecnica federale di Losanna e l'Università dell'Alabama a Birmingham. "Le cellule del nostro corpo non vivono isolate: interagiscono tra di loro e l'ambiente che le circonda, sperimentando una sorta di 'vita sociale'", osserva Riccardo Rizzo, ricercatore Cnr-Nanotec e coordinatore dello studio. "Grazie a tecniche avanzate di microscopia e analisi proteomiche, abbiamo dimostrato che la rigidità dei tessuti in cui si trovano le cellule può influenzare il modo in cui queste rilasciano sostanze all'esterno: in particolare, quando le cellule crescono su superfici più rigide, aumentano la loro capacità di secrezione, cioè il rilascio di proteine. Questo processo è fondamentale per la comunicazione tra cellule e per il corretto funzionamento dei tessuti, e ha importanti implicazioni per il trattamento di patologie come fibrosi e tumori". In queste condizioni patologiche, spiegano i ricercatori, i tessuti diventano più rigidi e inducono le cellule a secernere ulteriori proteine, che a loro volta rendono i tessuti ancora più duri innescando un circolo vizioso che alimenta la progressione della malattia.
D.Suarez--GM




